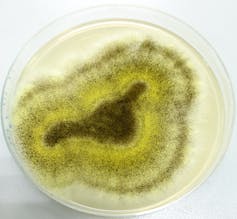

Microduendes: los microorganismos que nos ayudan a celebrar la Navidad

María Teresa Tejedor Junco, Universidad de Las Palmas de Gran Canaria
En Navidad, tiempo de alegría y felicidad, cada persona tiene sus preferencias: ¿Reyes Magos o Papá Noel? ¿Portal de Belén o árbol de Navidad? ¿Cava o sidra? Mejor un poquito de todo. ¿Y qué tiene que ver la Microbiología con todo esto?
En un artículo anterior hablamos de la festividad de Halloween y los microorganismos. Ahora vamos a ver qué papel juegan estos en la celebración de la Navidad, para bien y para mal.
¿Qué encontramos bajo el árbol de Navidad?
Cuando hablamos del árbol de Navidad, casi siempre nos imaginamos un abeto. Estos se crían inicialmente en invernaderos guardería y, cuando alcanzan un tamaño adecuado, se trasplantan en el campo.
Se conoce como rizosfera a la zona del suelo que rodea la raíz del árbol. Para que los abetos crezcan sanos y alcancen el tamaño adecuado, es indispensable que se establezcan las relaciones apropiadas con los microorganismos de la rizosfera.
Las zonas donde crecen los abetos suelen tener suelos pobres en nitrógeno, lo que limita su crecimiento.

Existe un grupo de microorganismos que se mantiene a lo largo de toda la vida del abeto, desde las guarderías hasta que alcanzan su máximo desarrollo. Aportan nitrógeno al árbol y también otras sustancias que favorecen su crecimiento.
Los microorganismos beneficiosos de la rizosfera también ayudan a luchar contra los patógenos que pueden causar enfermedades al árbol. Además, le permiten tolerar mejor otros problemas, como la salinidad del suelo o el calor.
Así que, además de regalos, bajo el árbol de Navidad están los microorganismos que hacen que sea tan hermoso.
¿Empaquetamos los regalos?
Podemos envolver nuestros regalos con papel brillante o ponerlos en bolsas con dibujos navideños. En cualquier caso, ¿qué necesitamos para obtener papel? ¡Ya se lo pueden imaginar!
Sin árboles no habría papel. La mayoría de los árboles necesitan hongos asociados a sus raíces para poder crecer, ya que les ayudan a obtener los nutrientes que necesitan. Así tendremos madera, que posteriormente se procesará para fabricar papel.
Una vez que hemos abierto los regalos, el bonito papel va al contenedor. Los microorganismos ayudarán a reciclar éste y otros residuos, devolviendo los nutrientes al medio ambiente para que el ciclo vuelva a empezar.
Chocolate calentito o en bombones y dulces
Sin microorganismos no tendríamos chocolate. ¡Eso acabaría con mi espíritu navideño!

Necesitamos a los hongos microscópicos en dos etapas de la producción del chocolate. Por un lado, son imprescindibles para que el árbol del cacao crezca adecuadamente. Forman una simbiosis: éste les aporta los azúcares que fabrica mediante fotosíntesis, mientras que ellos le ayudan a obtener agua y nutrientes del suelo.
En segundo lugar, las semillas de cacao son muy amargas y ácidas. Para que pierdan ese mal sabor, deben ser fermentadas por dos hongos: Candida krusei y Geotrichum sp.
La cena de Navidad no sería lo mismo sin los microorganismos

Vino, Champagne, cerveza… Para producir todas estas bebidas es necesario que una levadura, (Saccharomyces cerevisiae), lleve a cabo la fermentación alcohólica de los azúcares.
Algunas bebidas sin alcohol, como los refrescos de cola, llevan ácido cítrico. Para producirlo, se necesita un hongo microscópico, Aspergillus niger.
Además, las bacterias y los hongos intervienen en la producción de muchos de los aperitivos habituales: queso, encurtidos (pepinillos en vinagre), aceitunas, embutidos, etc.
Por otro lado, en la elaboración del pan, galletas, pasteles, puddings y todos los productos de bollería y panadería se utiliza la “levadura de panadero”, que hace que la masa suba.
Para conseguir muchos otros de los productos que utilizamos en nuestras recetas, como el yogurt o la salsa de soja, también intervienen microorganismos.
Y al final: café. ¿También aquí tienen algo que ver? Sí, ya que una etapa fundamental en el procesamiento de los granos de café es la fermentación. Las bacterias del ácido láctico desempeñan un papel importante y positivo en este proceso.
¿Qué comen los renos del trineo de Papá Noel y los camellos de los Reyes Magos?
En la tundra helada, los renos se alimentan de líquenes, sobre todo del llamado “liquen de los renos” (Cladonia rangiferina). Abundan en el polo norte y gracias a ellos, estos animales consiguen sobrevivir en la zona ártica.
Los líquenes son el resultado de la simbiosis entre un hongo y un alga (o a veces una cianobacteria).

Llega el turno a los camellos, que tienen el estómago dividido en 3 compartimentos. Estos se alimentan de hierbas y pueden comer incluso plantas espinosas, gracias a la forma de sus labios.
Esta vez es en la microbiota rumial, cuya principal función es la de digerir el alimento vegetal, donde se encuentran las bacterias, protozoos, arqueas y hongos.
Estos microorganismos ayudan a los camellos a obtener todos los nutrientes posibles a partir de alimentos con baja calidad nutritiva y difíciles de digerir. Así, podrán tener fuerzas para realizar su largo viaje hasta llegar a Belén.
Los animales que aportan calor al Portal de Belén
En el Portal de Belén tenemos más animales: la mula y el buey, que es un rumiante.
La digestión en el rumen es un ejemplo de mutualismo entre animales y microorganismos intestinales. Los rumiantes consumen hierba, hojas y ramitas ricas en celulosa. Por su parte, el rumen alberga grandes poblaciones de protozoos y bacterias que contribuyen a la digestión.

Éstos convierten la celulosa, el almidón y otros nutrientes en dióxido de carbono, hidrógeno gaseoso, metano y ácidos orgánicos de bajo peso molecular. El dióxido de carbono y el metano producidos en el rumen por la fermentación de los metanógenos se expulsan al exterior.
La liberación de metano y dióxido de carbono genera calor, pero también tiene sus riesgos.
Microduendes traviesos que nos pueden estropear la Navidad
Muchas de las comidas de estas fiestas se preparan con antelación. Eso hace que sea más probable su contaminación microbiana. En otros casos, el tamaño de las piezas cocinadas hace que sea difícil que en el centro del alimento se alcance la temperatura suficiente para eliminar las bacterias.

Los pavos, suelen tener Clostridium perfringens en sus intestinos. Hay que retirarlos cuidadosamente, y asegurarse de que se alcancen temperaturas superiores a 75ºC en su interior al cocinarlo. Tras la comilona, habrá que guardar las sobras en pequeñas porciones en la nevera. La intoxicación por este microorganismo es bastante frecuente y sus efectos pueden durar semanas.

Phytophthora infestans es un microorganismo que afecta a los cultivos de papas. Puede arrasar cosechas enteras. Como dato curioso, fue responsable de “la hambruna de la patata”, que causó la emigración de miles de irlandeses a EEUU a finales del siglo XIX.
Salmonella, Listeria y otros microorganismos también pueden dejar un mal recuerdo de las comidas navideñas. Para evitarlo, es importante seguir las medidas higiénicas al preparar los alimentos.
Al terminar el festín, no se debe dejar la comida sobrante en la mesa y a temperatura ambiente mucho tiempo. Lo ideal es dividirla en pequeñas porciones (para que se enfríe antes) y guardarla en la nevera.
De esta manera evitaremos toxiinfecciones alimentarias.
Microduendes de 2021
Durante el 2020 los microorganismos en general y los virus en particular han hecho que nuestra vida cambie radicalmente.
La pandemia de covid-19 nos ha afectado de muchas maneras. Extrañaremos más que nunca a los que nos han dejado y faltarán familiares y amigos en nuestras celebraciones.
Muchas de las tradiciones, como la cabalgata de Reyes o las visitas a los belenes, tendrán que suspenderse o hacerse de forma virtual.
Esta Navidad, en definitiva, será diferente. Lo principal es seguir manteniendo las precauciones.
Ojalá en 2021 los microorganismos buenos vuelvan a recuperar el protagonismo y “el coronavirus” se transforme en el fantasma de la Navidad pasada. Hasta que esto ocurra, cuídense y cuiden a los demás. ¡Feliz Navidad y Feliz 2021!